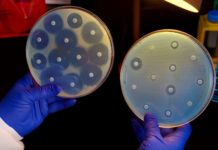
New Antibiotic Susceptibility Test Detects Resistance In Less Than 30 Minutes

Govt Job @ NCERT, Delhi – Junior Project Fellow Post Vacant For Life Science...
No.F./6.03//2017-18/DESM/
Department of Education in Science and Mathematics
NATIONAL COUNCIL OF EDUCATIONAL RESEARCH AND TRAINING
Sri Aurobindo Marg, New Delhi- 110016
Subject: Recruitment of one Junior...
Govt Job : 36 RA & 32 SRF Post Vacant @ Directorate of Plant...
Government of India
Ministry of Agriculture & Farmers
Welfare
(Department of Agriculture, Cooperation)
& Farmers Welfare)
Directorate of Plant Protection,
Quarantine & Storage
Sub: Notification for engagement...
Biotecnika Times – Newsletter 16.08.2017
Research Scientist Post @ NIH | Biotech Candidates Eligible - Salary up to Rs. 70,000/- p.m.
Advertisement for selection of Project Staff through Walk-in Interview...
Obscure Gene Opens New Possibilities For Novel Liver Cancer Therapies
The solute carrier family 13 member 5 (SLC13A5), a sodium-coupled citrate transporter, plays a key role in importing citrate from the circulation into liver...
Epigenetic Study Discovers New Neurons Types
Neurons are the brain cells that store and process information. There are about 100 billion neurons in an adult human brain and we have...
CRISPR-Edited Pigs Could Possibly Solve The Organ Shortage Problem
Its real offensive when someone says “pig-ugly”. Pigs are just as cute as your conventional pets, and contrary to popular belief they are intelligent,...
New Antibiotic Susceptibility Test Detects Resistance In Less Than 30 Minutes
Antibiotic resistance is a global threat to human health. The emergence and spread of antibiotic-resistant bacteria are aggravated by incorrect prescription and use of...
SRF Post Vacant for Project on Metabolic Engineering of Bacillus @ IIT Guwahati
Applications are invited for a Walk in interview for the following post(s) in the project entitled, "Metabolic Engineering of Bacillus megaterium for enhanced production...
Thyrocare Hiring For the Post of Publication Officer – PhD Life Science candidates Apply
Thyrocare Technologies Limited is India's first fully automated diagnostic laboratory with a focus on providing quality at affordable costs to laboratories and hospitals.
With a...
Pondicherry University Hiring Guest Faculties in Food Science and Nutrition Department
PONDICHERRY UNIVERSITY
DEPARTMENT OF FOOD SCIENCE AND TECHNOLOGY
WALK IN INTERVIEW FOR APPOINTMENT OF GUEST FACULTY
Interested eligible candidates may attend the walk in interview along...
NICED Hiring Msc / PhD Life Science Candidates For Research Associate Post at Rs...
The following post is to be filled up on purely temporary basis under the project entitled “Apoptosis and molecular targeting therapy in cancer by...
Biotecnika Times – Newsletter 14.08.2017
Drugs Controller General (India), MoH&FW Recruiting Research Scientists | Salary : Rs 50,000/- pm
Drugs Controller General (India), MoH&FW intends recruiting a suitable person
against the...
Drugs Controller General (India), MoH&FW Recruiting Research Scientists | Salary : Rs 50,000/- pm
F. No.A.12016/02/2015-D
Directorate General of Health Services
Central Drugs Standard Control Organization
Vacancy of Research Scientist (Medical Device & Diagnostics), CDSCO
Drugs Controller General (India), MoH&FW intends recruiting...
ICMR- JRF 2017 Result Notification
Dear Candidates,
ICMR JRF - 2017 Results Notification is out. Check your result below.
Biotecnika Times – Newsletter 11.08.2017
Important CSIR Announcement !
This is for general information of all CSIR Research Fellows/ Associates working in R&D Institutions, Universities, IITs and Colleges etc.............. Read More
Gandhian...